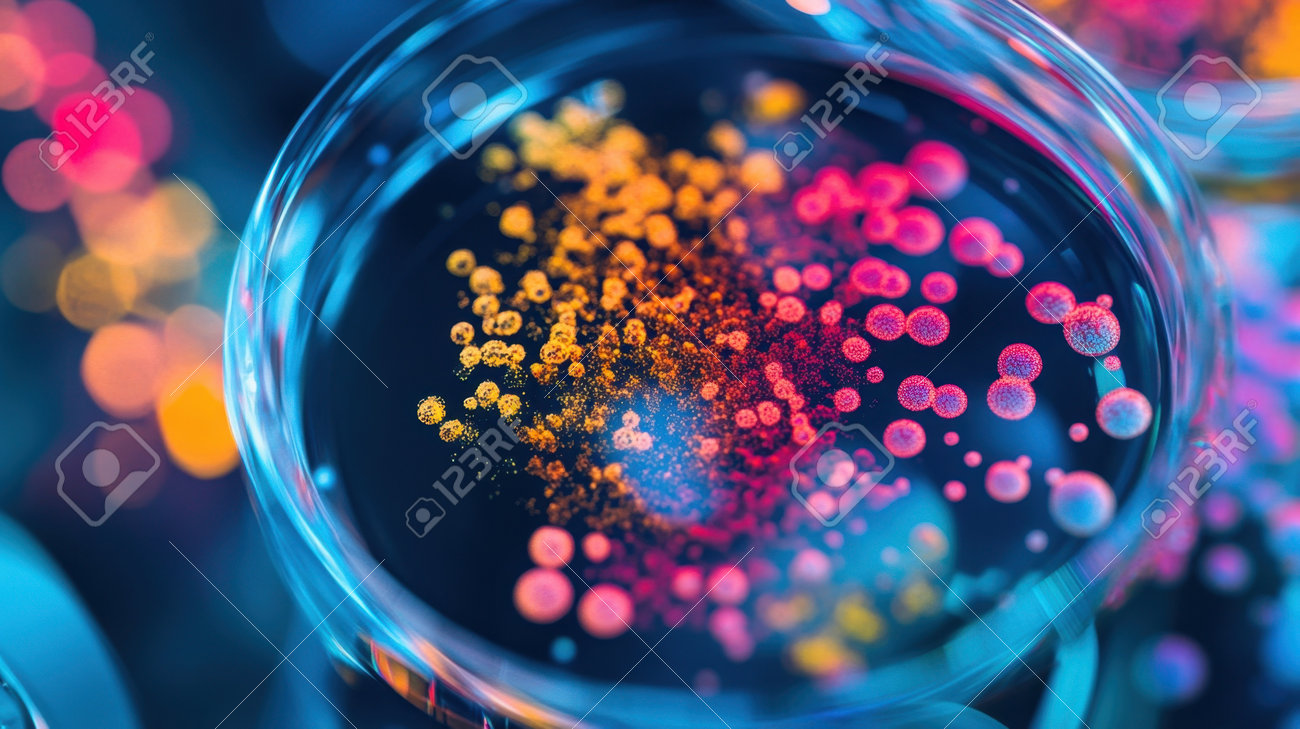
etiam-dictum-ipsum-a-felis

Download
Close
Автор:
id:
Ключевые слова:
analysis, art, bacteria, biological, biology, cellular, colonies, colorful, colors, culture, discovery, dish, equipment, experiment, exploration, fungi, growth, lab, laboratory, microbial, microbiological, microbiologists, microbiology, microorganisms, microscope, observation, patterns, petri, research, science, scientific, setting, structures, study, vibrant, work,





